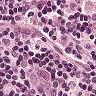

Symmetry, where certain features remain invariant under geometric transformations, can often serve as a powerful prior in designing convolutional neural networks (CNNs). While conventional CNNs inherently support translational equivariance, extending this property to rotation and reflection has proven challenging, often forcing a compromise between equivariance, efficiency, and information loss. In this work, we introduce Gaussian Mixture Ring Convolution (GMR-Conv), an efficient convolution kernel that smooths radial symmetry using a mixture of Gaussian-weighted rings. This design mitigates discretization errors of circular kernels, thereby preserving robust rotation and reflection equivariance without incurring computational overhead. We further optimize both the space and speed efficiency of GMR-Conv via a novel parameterization and computation strategy, allowing larger kernels at an acceptable cost. Extensive experiments on eight classification and one segmentation datasets demonstrate that GMR-Conv not only matches conventional CNNs' performance but can also surpass it in applications with orientation-less data. GMR-Conv is also proven to be more robust and efficient than the state-of-the-art equivariant learning methods. Our work provides inspiring empirical evidence that carefully applied radial symmetry can alleviate the challenges of information loss, marking a promising advance in equivariant network architectures. The code is available at https://github.com/XYPB/GMR-Conv.
翻译:暂无翻译